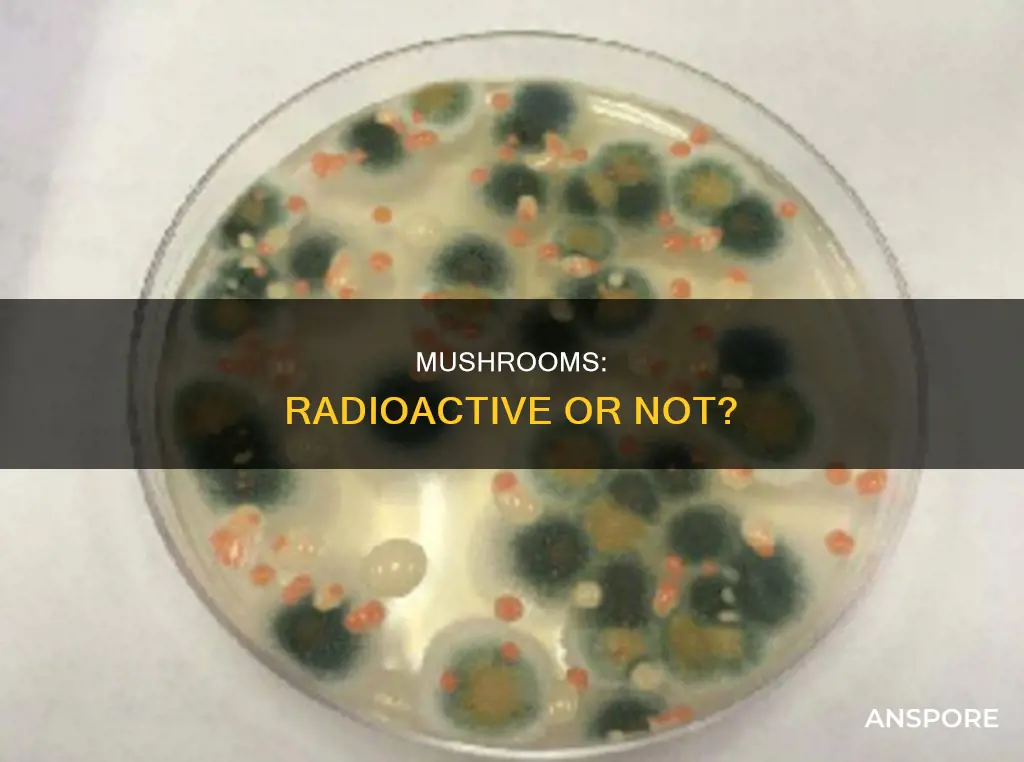
are mushrooms radioactive

Mushrooms are a complementary food source that has traditionally been consumed locally. However, the demand for mushrooms has surged in recent years, and the mushroom trade is becoming global. The consumption of wild mushrooms has been linked to increased body content of radiocaesium, a long-lived anthropogenic radionuclide. Certain species of mushrooms, particularly in Germany, still exhibit radioactive contamination from the 1986 Chernobyl nuclear disaster. This contamination is attributed to the accumulation of radionuclides, such as caesium-137, in the mushrooms' environment. Interestingly, some mushroom species, known as radiotrophic fungi, possess the unique ability to thrive in radioactive environments by converting gamma radiation into energy for growth. Additionally, ongoing research suggests that the melanin in mushrooms may offer protection against radiation exposure, presenting potential benefits for military personnel in radiation-prone situations.
| Characteristics | Values |
|---|---|
| Radioactivity in mushrooms | A health hazard |
| Radiation exposure of mushrooms and game | Caesium-137 |
| Radioactive contamination | Chernobyl nuclear disaster |
| Radioactivity in mushrooms | Radiocaesium |
| Radioactivity in mushrooms | A protective shield |
Explore related products
What You'll Learn
- Mushrooms can be a health hazard in areas with high levels of radioactivity
- Radioactivity in mushrooms is mainly analysed through radiocaesium content
- Radioactivity in mushrooms can be caused by nuclear accidents, such as Chernobyl
- Some mushrooms can survive in radioactive environments and even thrive
- Mushrooms can protect against radiation due to their high melanin content

Mushrooms can be a health hazard in areas with high levels of radioactivity
Mushrooms are considered excellent bioindicators of environmental pollution. They can absorb and accumulate radionuclides from the soil, which can pose a health hazard to humans and livestock that consume them. This is especially true in areas with high levels of radioactivity due to nuclear accidents or weapons testing. For example, mushrooms in Germany still show radioactive contamination from the 1986 Chernobyl nuclear disaster, with elevated concentrations of caesium-137 and caesium-134 isotopes found in southern Germany. Similarly, the consumption of wild mushrooms in areas affected by the Chernobyl fallout led to increased body content of radiocaesium in the population.
The contamination of mushrooms depends on both the level of radionuclides in the soil near the mycelium and the accumulation capacity of the mushroom species. Certain species of mushrooms, known as radiotrophic fungi, have the unique ability to not only survive but thrive in radioactive environments. They are believed to use melanin to convert gamma radiation into energy for growth. While the presence of melanin in the digestive tract may offer some protection against radiation exposure, consuming mushrooms with high levels of radionuclides can still pose a health risk.
The demand for wild edible mushrooms has increased globally, and their consumption is considered a delicacy in many countries. This has led to a significant rise in the distribution of these products. However, the origin of mushrooms is often obscured from consumers, and they may unknowingly purchase mushrooms from contaminated areas. To reduce their exposure to radioactive mushrooms, consumers should avoid excessively eating wild mushrooms or game hunted in areas known to have high levels of radioactivity, such as those affected by the Chernobyl accident.
Regulatory bodies, such as the German food safety regulator, monitor the radioactive content of mushrooms to ensure they do not exceed legal limits. In Germany, none of the 74 samples tested exceeded the legal limit of 600 becquerels of radiation per kg. However, it is important to note that the radioactive material can linger in forest ecosystems for extended periods due to their efficient nutrient recycling. As a result, wild mushrooms may continue to show contamination for many years, and the activity concentrations will gradually decrease over time.
Pluteus Mushrooms: Do They Contain Psilocybe?
You may want to see also

Radioactivity in mushrooms is mainly analysed through radiocaesium content
The radioactivity of mushrooms has been a topic of interest for many years, especially in the context of nuclear accidents and their impact on the environment. Mushrooms are known to accumulate radionuclides, which can pose a health risk when consumed by humans or livestock. While various radionuclides can be present in mushrooms, the analysis of their radioactive content has primarily focused on radiocaesium, specifically caesium-137.
Caesium-137 is a long-lived anthropogenic radionuclide with a half-life of 30.2 years. It has been introduced into the environment through nuclear weapons testing and accidents, such as the Chernobyl disaster. Due to their ability to absorb and accumulate radionuclides, mushrooms in certain regions, particularly in Germany and Italy, have been found to be contaminated with caesium-137 even decades after the Chernobyl accident. The contamination levels vary depending on the caesium-137 concentration near the mycelium and the accumulation capacity of the specific mushroom species.
The focus on radiocaesium in mushrooms is twofold. Firstly, as an anthropogenic radionuclide, it has been released into the environment through human activities, and its presence in mushrooms can provide insights into the extent and persistence of radioactive contamination. Secondly, radiocaesium is a chemical analogue of potassium, which is essential for human health. This similarity can have implications for the uptake and accumulation of radiocaesium in the human body through the consumption of contaminated mushrooms.
The analysis of radiocaesium content in mushrooms is crucial for assessing the potential health hazards associated with mushroom consumption in contaminated areas. While most of the discussed studies focus on wild mushrooms, it is important to note that cultivated mushrooms can also be affected by radioactive contamination. For example, after the Fukushima accident, the consumption and distribution of log-cultivated shiitake mushrooms were restricted until their radioactive content fell below regulatory values.
In summary, the analysis of radiocaesium content is vital for understanding the extent and potential health risks of mushroom contamination in areas affected by radioactive fallout. By studying the radiocaesium levels in mushrooms, scientists can assess the environmental impact of nuclear accidents and provide recommendations for protecting public health.
Puffball Mushrooms: Reproductive Strategies and Life Cycles
You may want to see also

Radioactivity in mushrooms can be caused by nuclear accidents, such as Chernobyl
Radioactivity in mushrooms is a well-known phenomenon, with certain species of mushrooms being highly contaminated with radioactive isotopes, particularly caesium-137. This contamination is often a result of nuclear accidents, such as the infamous Chernobyl disaster, which released large amounts of radionuclides into the environment.
The Chernobyl accident, which occurred in April 1986, contaminated vast areas of Ukraine, Belarus, and Russia with radioactive isotopes. This included caesium-137, which has a relatively long half-life of 30 years, allowing it to persist in the environment for extended periods. The contamination of mushrooms, in particular, has been a significant concern due to their ability to accumulate radioactive isotopes.
Mushrooms have a unique ability to bioaccumulate radioactive isotopes, including caesium-137, from the environment. This means that they can concentrate these isotopes within their tissues, resulting in high levels of radioactivity. In the case of Chernobyl, wild mushrooms in the affected areas were found to contain high levels of caesium-137, even decades after the accident. This led to increased body content of radiocaesium in the local population who consumed these mushrooms.
The contamination of mushrooms with radioactive isotopes can have significant health implications. The consumption of contaminated mushrooms can result in internal radiation exposure, posing a risk to human health. As a result, it is recommended that people avoid consuming wild mushrooms from areas known to be contaminated by nuclear accidents, such as Chernobyl.
Additionally, the study of radiotrophic fungi, which are capable of utilising radiation as an energy source, has emerged as a potential solution to the challenges of radioactive waste cleanup. These fungi, including Cladosporium sphaerospermum, have been found in high-radiation environments like Chernobyl and exhibit accelerated growth rates compared to non-radioactive conditions. The ability of these fungi to harness radiation and their potential role in bioremediation offers hope for addressing environmental challenges associated with radioactive waste.
Mushrooms: Diabetic Superfood or Sugar Bomb?
You may want to see also
Explore related products

Some mushrooms can survive in radioactive environments and even thrive
Mushrooms are considered excellent bioindicators of environmental pollution. They can accumulate radionuclides, which can pose a radiological hazard if consumed by humans or livestock. Certain species of mushrooms are still highly contaminated with caesium-137 in some areas of Germany, mainly due to the Chernobyl nuclear disaster. Similar contamination has been observed in northeast Italy and other areas affected by nuclear accidents, such as Fukushima. The consumption of wild mushrooms in these areas has led to increased body content of radiocaesium in the population.
However, it is important to note that some mushroom species have developed the unique ability not just to survive but also to thrive in radioactive environments. These growths, known as radiotrophic fungi, are believed to use melanin to convert gamma radiation into energy for growth. The presence of melanin in mushrooms has been found to offer protection from high doses of radiation when present in the digestive tract. This has led to potential applications in radiation protection for military personnel and those working in radiological or nuclear environments.
The study of radiotrophic fungi and their ability to convert radiation into energy offers exciting possibilities for both radiation protection and the detection of nuclear activity. By understanding how these fungi interact with radioactive materials, researchers can explore new ways to harness this ability for practical applications. This includes the potential use of fungi-based detectors for nuclear testing and the development of radiation shields for human protection.
While the consumption of wild mushrooms in contaminated areas is generally discouraged due to the risk of radiological hazards, the unique properties of radiotrophic fungi highlight the complex relationship between mushrooms and radiation. Further research in this field may uncover additional benefits and applications, contributing to our understanding of radiation protection and providing new tools for addressing radioactive environments.
Mushroom Trees: Where Do They Come From?
You may want to see also

Mushrooms can protect against radiation due to their high melanin content
Mushrooms are known to accumulate radioactive material, particularly in areas with high levels of nuclear fallout, such as Chernobyl. This has resulted in health hazards for humans who consume these mushrooms, with cases of increased body content of radiocaesium observed in the population.
However, some mushrooms have been found to possess radiotrophic properties, meaning they can not only survive but also thrive in radioactive environments. These radiotrophic fungi have been observed to direct their growth towards sources of beta and gamma ionizing radiation, exhibiting a phenomenon known as "radiotropism".
The key to their radiation resistance lies in their high melanin content. Melanin is a dark-colored pigment that can absorb electromagnetic radiation due to its molecular structure. This absorption of radiation is believed to protect the fungi from its harmful effects, acting as a radiation shield. In fact, melanotic fungi have been found in some of the most extreme environments, including the Chernobyl Nuclear Power Plant, demonstrating their remarkable ability to withstand high levels of radiation.
The potential of melanin in radiation protection has been demonstrated in mice studies. When given fungal melanin, mice were able to survive lethal doses of gamma irradiation. This protective effect is attributed to melanin's ability to protect the digestive tract and associated lymphatic tissue from radiation damage.
Furthermore, the application of melanin from fungi for radiation protection in humans is being explored. Research by Ekaterina (Kate) Dadachova suggests that consuming black mushrooms protected mice from high doses of external radiation. While the protection is temporary, the presence of mushroom melanin in the digestive tract during a radiation influx can offer significant shielding effects. This discovery could lead to new avenues for protecting individuals, such as soldiers and military personnel, who may encounter elevated levels of radiation in their line of work.
Bella Mushrooms: Frying Up a Storm
You may want to see also
Frequently asked questions
Mushrooms are not inherently radioactive, but they can become contaminated with radioactivity from the environment. Certain species of mushrooms in some areas of Germany still show radioactive contamination from the 1986 Chernobyl nuclear disaster.
Mushrooms can accumulate radionuclides, such as radiocaesium, from the environment, which makes them radioactive. The contamination of mushrooms depends on both the level of caesium-137 near the mycelium and the accumulation capacity of the mushroom species.
No, the contamination of mushrooms is very site-specific and can vary significantly even within the same area. Additionally, some species of mushrooms, known as radiotrophic fungi, have the unique ability to not only survive but thrive in radioactive environments by using melanin to convert gamma radiation into energy for growth.










































